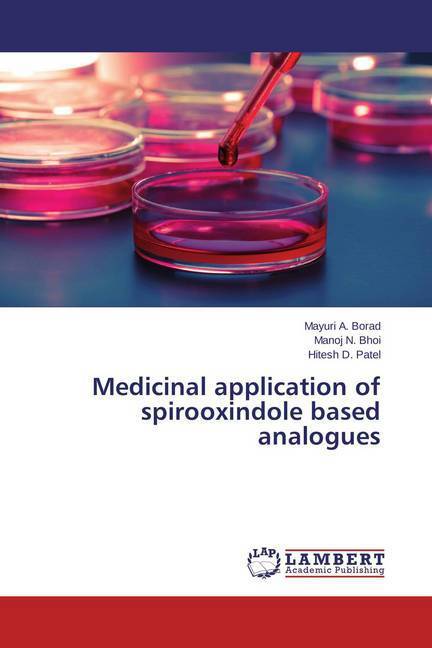

Je cadeautjes zeker op tijd in huis hebben voor de feestdagen? Kom langs in onze winkels en vind het perfecte geschenk!
- Afhalen na 1 uur in een winkel met voorraad
- Gratis thuislevering in België vanaf € 30
- Ruim aanbod met 7 miljoen producten
Je cadeautjes zeker op tijd in huis hebben voor de feestdagen? Kom langs in onze winkels en vind het perfecte geschenk!
- Afhalen na 1 uur in een winkel met voorraad
- Gratis thuislevering in België vanaf € 30
- Ruim aanbod met 7 miljoen producten
Zoeken
Medicinal application of spirooxindole based analogues
Mayuri A. Borad, Manoj N. Bhoi, Hitesh D. Patel
Paperback | Engels
€ 39,95
+ 79 punten
Omschrijving
The chemistry and an extensive spectrum of biological activities of spirooxindole have been examined since several decades and this heterocyclic core has received emerging consensus. This content aims to summarize recent advances made towards the discovery of Antituberculosis activity, AChE and BChE inhibitory activity, Anti-tumor activity, Antibacterial and Antifungal activity and Miscellaneous Activity holding spirooxindole as a nucleus with the substitution of several types of nucleophiles, and molecular patterns associated with particular potency have been identified targeting several Gram-positive and Gram-negative bacteria and some fungal species, mycobacterium tuberculosis H37Rv, and drug-resistant tuberculosis (XDR-TB), Alzheimer's disease, HCT 116 (colon), MCF 7 (Brest) and HEPG 2 (liver) human tumor cell lines. The report will be of enormous interest to gain useful information for the furtherance of drug discovery with extended spirooxindole designs.
Specificaties
Betrokkenen
- Auteur(s):
- Uitgeverij:
Inhoud
- Aantal bladzijden:
- 60
- Taal:
- Engels
Eigenschappen
- Productcode (EAN):
- 9783659717260
- Verschijningsdatum:
- 4/06/2015
- Uitvoering:
- Paperback
- Afmetingen:
- 150 mm x 220 mm
- Gewicht:
- 100 g

Alleen bij Standaard Boekhandel
+ 79 punten op je klantenkaart van Standaard Boekhandel
Beoordelingen
We publiceren alleen reviews die voldoen aan de voorwaarden voor reviews. Bekijk onze voorwaarden voor reviews.